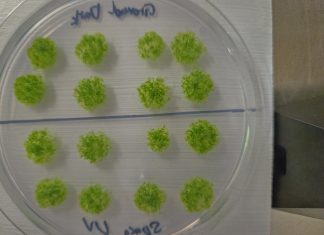
Мох выжил в открытом космосе: споры растения провели 9 месяцев снаружи МКС

В Китае представлен новый Toyota Wildlander — клон новейшего Toyota RAV4 за 170 тыс....
С полным приводом e-Four и комплексом систем Toyota Safety Sense 4.0 ...
Новинка Samsung, которую можно будет надеть на лицо. Раскрыты некоторые подробности об умных очках...
Они будут максимально похожими на обычные очки ...
Мох выжил в открытом космосе: споры растения провели 9 месяцев снаружи МКС
Открывая перспективы для создания устойчивых экосистем на других планетах ...
Для гигантов и с 3D-экраном. Портативную игровую консоль Abxylute 3D One уже можно заказать...
Пока через Kickstarter ...
В России запустили первого ИИ-ассистента для обращения граждан к мировым судьям
Также будет создан ИИ-агент, который поможет судьям принимать решения и сможет генерировать их автоматически ...
Apple начала продавать уценённые iPad Air 2025 года
Гарантия на такие планшеты — один год ...
Самый мощный ракетный ускоритель в истории во всей красе: SpaceX начала выкатку ускорителя Super...
Для ракеты Starship третьего поколения ...
Snapdragon 8 Gen 5, какая-то камера разрешением 200 Мп и складной экран. Появились первые...
Новинка ожидается в ближайшее время ...